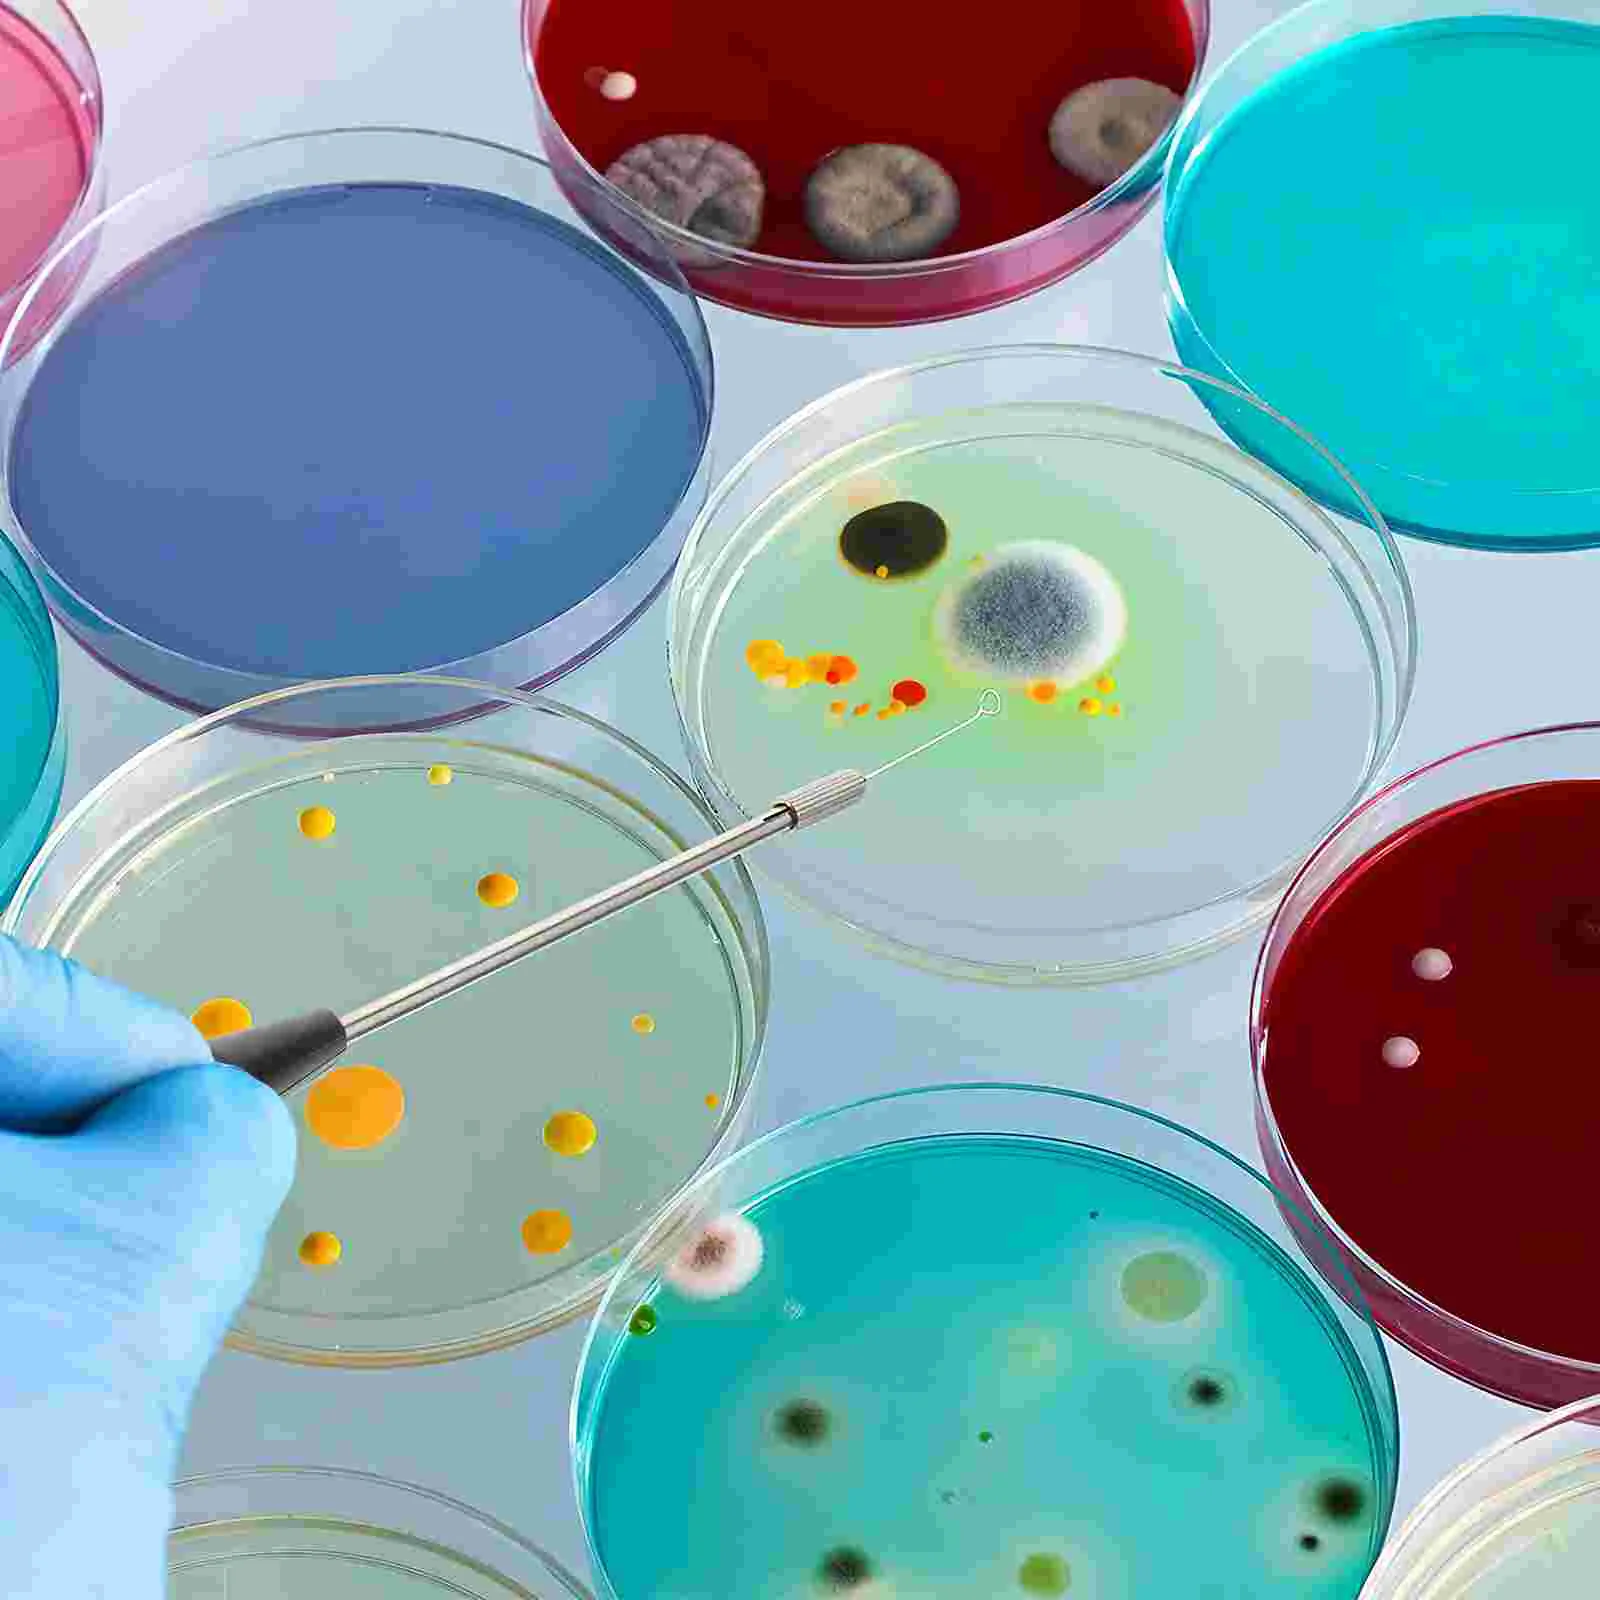
thumb

92 Pcs Inoculation Loop Microbiology Rod Rods All Bronze Teaching Equipment Reusable Inoculating Copper
Price history chart & currency exchange rate
Customers also viewed

$6.65
G7ND Essential Motorcycle Accessory Bag Practical Motorcycle Seats Bag for R1300GS
aliexpress.com
$21.07
181H Racing Steering Wheel Short Hub Adapter Fit For VW Golf / Jetta / Passat / Seat Ibiza / Volkswagen Corrado
aliexpress.com
$73.74
Women's 23 years new niche asymmetric collar colour blocking suit bottoming sheath dress Slim thin suit
aliexpress.ru
$15.81
Пленка для ЖК-экрана для Ford Kuga Escape 2020-prescontrol, Стайлинг автомобиля, пленка для экрана GPS-навигации, Защитная пленка для экрана
aliexpress.ru
$5.08
Cartoon-P-Powerpuff-Girl POSTER Poster Prints Wall Pictures Living Room Home Decoration Small
aliexpress.com
$429.07
Зеркало настенное золотистое в гостиную, роскошное минималистичное зеркало в полную длину для спальни, GXR35XP
aliexpress.ru
$0.90
Женские стельки с пятью пальцами, средние стельки для снятия боли в передней части стопы, на высоком каблуке, защита мозолей, мозоли, 1pai Q8H2
aliexpress.ru
$15.25
Новинка 2022, осенне-зимний жилет с капюшоном, пуховая хлопковая куртка, женские парки, облегающее пальто без рукавов, утепленная Повседневная Верхняя одежда на молнии, жилет
aliexpress.ru
$14.79
Модель автомобиля литая из металлического сплава, модель автомобиля 1:32 Porsche 911 Turbo S, игрушки для мальчиков, игрушки на день рождения, коллекция автомобиля, E197
aliexpress.ru
$30.40
Набор столовый "Этель" Olivia, скатерть 110х150 см, салф. 40х40 см-4шт, 100% хл Этель, Разноцветный, 000283053
goods.ru
$38.65
summer new soft-soled men's beach shoes outdoor casual non-slip sandals fashion trend sandals men's factory direct sales
fordeal.com
$61.09
Replace Fuba Huba 511 pressure sensor imported from Switzerland, pressure transmitter 400bar 4-20mA
aliexpress.com
$22.61
women's jeans 2021 fashion wild casual big hole small feet pants personality honing broken elastic trousers, Blue
dhgate.com
$26.16
women's swimwear wrap around swimsuit serpentine leopard printed monokini bandage bathing suit deep v 3922 79b0, White;black
dhgate.com
$46.65
Мужская модная обувь с принтом в виде милой собаки; Новые кроссовки; Мужская повседневная обувь; Весенняя удобная мужская дышащая обувь с бе...
aliexpress.com
$115.42
Motorcycle Accessories Real Carbon Fiber Muffler Exhaust Pipe Cover Heat Shield Decoration Parts for Yamaha MT07 FZ07 2014-2017
aliexpress.com
$439.00
Золотистая и розовая балерина Prima, балетная пачка, молодежная американская цена, яркая фотография, на продажу BT660
aliexpress.com
$1,665.02
TWITTER E5e bike KRISTALL mountain electric power bicycle lithium battery speed off-road 26/27.5/29 inchbicicleta electric bike
aliexpress.com
$92.11
sandals 2021 platform comfortable thick bottom white black beach shoes magic tapes candy color summer women's wedge
dhgate.com
$11.65
bowls 8x6cm salad bowl fruit decoration practical wooden household kitchen cutlery basin storage
dhgate.com
$31.72
sandals leosoxs men gladiator male shoes slip-on flat flip flops mens casual 2021 summer beach, Black
dhgate.com
$26.36
japanese and korean solid color cotton hemp lapel short sleeve loose pocket women's casual dress, Black;gray
dhgate.com
$22.62
Women-s Faux Fur Hooded Waistcoat-s Leopard Long Vest Autumn Animal Printed Slim Colete Girls Winter Warm Vintage Brown Jackets
aliexpress.com